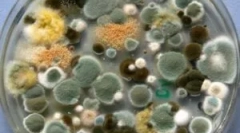
Typy, zloženie a vlastnosti formy

Typy orchideí fotografie a tituly
Vsebina
Mnohí ľudia poznajú vnútornú rastlinu Orchidea: fotografia nezvyčajne krásnych odrôd s menami odrôd vyplní akékoľvek vydanie pre kvetináč. Pri návšteve kvetinového salónu alebo výstavy epifytov je prirodzený pocit pôžitku z prírodných tvorov. Ale pôvabné kvety s Wrencuts podobnými tropickým motýľom, môžu ozdobiť nielen skleník, ale aj systém Windows obyčajného mesta City.
Orchidy doma
Legenda o ľuďoch Maori hovorí o tom, že tropické orchidey boli vytvorené z dúhových fragmentov. Oni náhodne závislé za strommi a nespadali do oceánu. Teraz plátky dúhy žijú na drevených kmeňoch, premenia sa na elegantné viacfarebné girllands kvetov na dlhých stonkách.
Koľko druhov orchideí existuje na svete, nemôže významne povedať aj tie najskúsenejšie nerd. V súčasnosti popisuje asi 1 tisíc. Divoké druhy, z ktorých mnohé sú ľahko hybridizované v prírodných podmienkach. To znamená, že vedci majú vždy možnosť odhaliť a popísať novú, stále neznáme vedecké kvety.
Umelo odvodené odrodové orchidey sa líšia ešte viac odrody: druhy a odrody týchto rastlín pestovaných v skleníkoch a apartmánoch majú viac ako 30 tisíc. Mená. Väčšina moderných hybridných odrôd sú dosť nenáročné. To robí orchidey populárnych domácich rastlín.
Ďalšou zložkou popularity nezvyčajných farieb je množstvo farieb a tvarov bielych. Tam sú odrody orchideí s bielymi, ružovými, žltými a dokonca takmer čiernymi alebo nazelenalými lístkami. Odrody sú najviac ocenené kombináciou niekoľkých odtieňov: majú kontrastné špinenie alebo čistý výkres, hladké prechody všetkých farieb dúhy na veľkých lístkoch, so samostatnými okvetnými lístkami alebo kvetinami, maľované inak ako iné. Spectip akejkoľvek fialovej orchidea: chovatelia dosahujú najtmavšie odtiene, snaží sa vytvoriť čierne kvety.
Až do nedávnej orchidey - vzácny hostia v apartmánoch. Existuje názor, že sú to veľmi zložité kvety. Ale aj nováčik amatérsky, môže dosiahnuť kvitnutie z takmer akejkoľvek rastliny ponúkanej v salónoch. Moderné typy domácich orchideí sú špecificky odvodené pre podmienky priemerného bytu. Všetko, čo potrebujú, je včasná zalievanie a teplota vzduchu nie je nižšia ako + 20 ° С.
Nádherný je vlastnosť orchideí na dlhú dobu, aby nezmial. Otvorenie, kvetina dokonca aj najjednoduchšie Phalaenopsis drží na šípku na niekoľko týždňov. Vzhľadom na to, že sú odhalené veľké fúzy a 20 ks. Na každom rozmazaní, môžete pochopiť mimoriadnu lásku k kvetinovej vode na tieto izbové rastliny. Obísť len niekoľko kríkov rôznych odrôd a druhov, môžete získať neustále kvitnúce zbierku epifytov. Mnohí z nich sú schopní kvitnúť a niekoľkokrát ročne, a druh orchideí z južnej pologule zvyčajne kvitnú v polovici zimy.
Kvet ako mol
To je, ako sa vedecký názov Faleenopsis orchideí prekladá. Nie je skutočne pravdivé ich ľudové meno - motýľové archívy. Toto sú najjednoduchšie rastliny v obsahu, ktoré sú vhodné pre prvú oboznámenie s rodinou orchideí. Ale ľahkosť starostlivosti nie je menej krásna.
Na základe divokých orchideí sa vytvárajú moderné odrody a hybridy, odlišujú sa od seba nie len vo farbe, ale aj vo forme a veľkosti kvetu. Existujú rastliny s dekoratívnymi listami (rôzne formy so zlatými pozdĺžnymi pruhmi). Medzi Phalaenopsis, ktoré sú vhodné na údržbu v pravidelnom byte, môžete si vyzdvihnúť niekoľko odrôd s inou farbou:
- Fialová orchidea čierna labuť (čierny labuť) je malá veľkosť. Výška sfarbenia dosahuje len 30 cm, ale približne 10 monofónnych kvetov s priemerom približne 3 cm. Vyzerá to ako čierne motýľové a čierne vlastné odrody, ale sú väčšie vo veľkosti (biele sú až 7 cm) a majú biele úseky vo farbe, čo robí rastlinu nezvyčajne dekoratívne. Ešte efektívnejšie fialová orchidová výnosová záblesk s takmer čiernymi lístkami a snehovo bielym jadrom. Jeho kvety dosahujú 5-7 cm veľkosti a výška šípky je 60 cm.
- Neha zozbieraných citrónových farieb Mandala odrody neopustí nikoho ľahostajným. Kontrastný lila odtieň bodov opakuje farbu rozmazanej kayma na horných okvetných lístkoch. V jadre kvetinových odtieňov žltej a lila sa bohatí a tvoria komplikovaný kruhový ornament. Kvety majú v priemere až 7 cm a šípky sú elegantne klenuté pod ich závažnosťou.
- Odrody s bielymi a ružovými okvetnými lístkami, je to jedna z najvyhľadávanejších farieb na trhu (používajú sa na kyticu nevesty). Niektorí majú kontrast maľované jadro (Darwin, Aljaška, Alabaster a Dr.).
- Obrovské množstvo odrôd Phalaenopsiss má mesh sfarbenie lístkov. Odtiene svetla a tmavých oblastí môžu byť doplnené v jednej farebnej schéme (najčastejšie ružové alebo lilac), ale existujú odrody s kontrastnými vzormi výkresu (fialové prúžky na pozadí oranžovej farby na odrode kaleidoskopu). Relatívne nový stupeň mesh Phalaenopsis Kimono má červené žily na citrónových lístkoch.
Novinkou na ruskom trhu je holandská Phalaenopsis Wild Cat (Wild Cat). Výška kvetov tejto odrody môže dosiahnuť 80 cm. Sú to dosť veľké orchidey, ktoré majú priemer chovateľov asi 8 cm. Farba okvetných lístkov je nezvyčajná: veľké škvrny burgundy sú rozptýlené na bielom pozadí. Bolesť skupiny môžu byť orámované tenkým prúžkom, ktorý dáva orchidnú podobnosť s leopardom kožušinou alebo divokými mačkami.
Modrá alebo modrá orchidea môže byť zakúpená len v dôsledku umelého tónovania. Nákup "vzácnej odrody" Phalaenopsis by nemal: čo naozaj vyzerá, pochopí ďalší kvet. Toto je spoločná biela odroda, pretože modré odtiene sú charakteristické pre jediný typ orchidey, slávny v spálni kvitnúce - wanda modrá.
Čo je kráľovská orchidea?
Biela kráľovská orchidea, ktorej fotografie často zdobia reklamné svadobné salóny, je typ phalaenopsis. Pre tieto rastliny, rozdelenie do skupín, ktoré sa nazývajú Mini, Standard a Royal. Nízke odporúčané pre pestovanie na parapete alebo stojanke a majú výšku od 10-15 cm (mini, najmenšie) až 60 cm (štandard).
Royal - najväčší z Phalaenopsis. Výška jeho kvetov dosiahne 1 m a viac. Loky sa nachádzajú lineárne, pretože Royal Phalaenopsis sa nebráni. Ale kvet vyzerá nádherný a môže byť použitý ako vonkajšie dekorácie interiéru.
Kráľovské rastliny a kvety neobvyklých hodnôt. Priemer kňučania každého z nich dosahuje 15 cm. Girlands týchto farieb sú veľmi veľkolepé s akoukoľvek farbou okvetných lístkov. Medzi najväčšie Phalaenopsis stretávajú aj odrody s rôznymi farbami bielych a listov.
Akákoľvek odroda Phalaenopsis kvitne 2-3 krát ročne. Tieto kvety môžu byť vyrobené z kolekcie, pretože sú nenáročné a prakticky neustále vo fáze aktívneho rastu a kvitnutia. Dokončite zbierku jednoduchšie pre rovnaké jednoduché v starostlivosti Dendrobioami.
Čo je Dendrobium?
Toto je rodu orchideí s kvetmi s charakteristickou formou: 3 zadné okvetné lístky menšie ako 2 strany, a pery (spodné lístky) je veľmi rozvinuté a natiahnuté dopredu. Pre mnohé odrody má vlnité hrany, a na druhu Dendrobium Nobile (Noble) hlboko strih. Veľkosti vence kolíšu v závislosti od veľkosti samotného závodu a vo veľkých skleníkových inštanciách môžu dosiahnuť priemer 10-15 cm.
Tree rastlina má kvety, ktoré sa nachádzajú na stonke (pseudobulb) k listom. V prírodných podmienkach, dendrobionov rastú tak dlho, že visia z kmeňov. Ale Ampel Forma nie je veľmi pohodlný doma, pretože veľká rastlina má veľa miesta. Výberové práce sa vykonávajú nielen zmenou farby kvetu, ale aj na výrobu závodu viac kompaktnejšie.
Hybridná bushová orchidea, viazaná na vertikálnu podporu, vždy vyzerá elegantne kvôli mnohým farbám asi 7 cm, pokrývajúci kmeň vo svojej výške. Niekoľko rastlín môže byť vysadených v hrnci dostatočnej veľkosti. Tento jednoduchý trik urobí kompozíciu ešte veľkolepom.
Derrobiums kvitnú kedykoľvek počas roka, ale niektoré odrody vyžadujú zníženie teploty na + 16 ° C, aby vyvolali kvetinovú obličkovú záložku. Kvitnúce rozmary držia na stopku až do 3-6 týždňov bez vyblednutia. Po kvitnutí sa rastlina obnoví listy.
Barrel alebo Pseudobulb, rastie 2-3 roky. Dcérske rastliny sú vytvorené na jeho špičke, potom, čo kmeň zomrie. Toto je prirodzený proces a model kvetov môže zasadiť novú malú orchidea v zemi, ktorá zdedí všetky známky odrody.
Doddbobium Noble orchidea má voňavé kvety, ktoré sú nepactaracteristické pre Phalaenopsis. Táto vlastnosť robí dendrobium obzvlášť populárne v kvetinovej vode. V súčasnosti sú odvodené mnohé odrody rastlín s ružovými lístkami.
Nedostatočné krásne orchidey skupiny YAMAMOTO. Názov hybridov bol povolaný menom šľachtiteľa, ktorý venoval svoje životy na odstránenie nových odrôd Dudrobium. Žltá Candy odroda orchidea, biela s lila tipy pre okvetné lístky (platina), ružová so žltou princeznou alebo všetkými farbami dúhy, prítomné v fantázie farbenie, môže ozdobiť akúkoľvek zbierku. Sortiment hybridných farieb dosahuje niekoľko stoviek.
Iné typy orchideí pre domácnosť
Medzi farby, ktoré možno nájsť v obchodoch, existuje viac náročných podmienok obsahu. Červená orchidea Miltonia sa bude cítiť dobre len v skleníku alebo v špeciálne vytvorených podmienkach s vysokou vlhkosťou. Ale rastlina má voňavé kvety a pomerne širokú škálu odtieňov z bielej až tmavej ružovej a červenej farby, takže sa teší veľmi populárne so skúsenými chovateľmi orchidov.
Biela škvrnitá orchidea Cumbria bola vytvorená na základe Miltonia a 2 ďalších druhov. Táto rastlina sa nenachádza vo voľne žijúcich živočíchov. Veľké hviezdne kvety sa nachádzajú na dlhých kvetoch a sú obklopené úzkymi listami pripomínajúcimi Amarillis. Bush má veľmi atraktívny pohľad počas obdobia kvitnutia (asi 4 mesiace, v lete). Závod bude vyhovovať podmienkam aj na parapete mestského bytu, ale hybrid je veľmi citlivý na sušenie substrátu.
Wanda Blue je jediný medzi príbuznými, ktorí majú tyrkysové maľovanie lístkov. Kefy jeho kvetenstiev dostávajú na dĺžku 30 cm a krásne zaveste, ak je kontajner s rastlinou umiestnený v kaši. Kvitne neskoro na jeseň a zachováva nádherný vzhľad až do nového roka. Existujú umelo odvodené odrody s intenzívnejšími maľovanými lístkami a kvetmi až 9 cm v priemere. Ružová alebo fialová orchidea Wanda nie je menej efektívne, ale tieto odtiene sú tiež charakteristické pre iné stupne, a nebeské lístky majú len tento druh.
Vzácne orchidey
V súčasnosti kultúra zaviedla niektoré vzácne odrody domácich orchideí. Zvláštnosťou je osobitná pozornosť na nasledujúce odrody a typy:
- Biela orchidea Cymbium s nezvyčajným klinom, z ktorých obrys sa podobajú zastrešeniu, u ľudí nazývaných anjelský kvet. Existujú typy so žltými, lilac, ružovými lístkami. Výberové formy sa stali kompaktnejšími a ponáhľajúcimi sa, môžu prežiť s nie najodrobnejším starostlivosťou.
- Braxia, alebo pavúk orchidea, je zarážajúci diváka s dlhými filamentnými okvetnými lístkami. Každá kvetina sa naozaj podobá pavúku s tenkými labkami a ich číslo na vertikálne umiestnenej šípke dosiahne 10-15 ks. Pre rastliny je charakterizované bielymi a zelenými farbami. Kvety kvitnú na jar, voňavé, ale vôňa sa môže zdať nepríjemné.
- Veľkolepé typy orchideí Dracula. Niektoré kvety sa podobajú opičí tvár, rôzne čierne lístky je odvodené (upír), ktorý má extravagantný a úžasný vzhľad.
- Biely voňavý strapec Ludiosia kvety nie je obzvlášť atraktívny. Tento typ kvetinových prístrojov je ocenený pre dekoratívne listy. Zamatový povrch dosky je pokrytý sieťou ružových alebo zlatých žíl, čo robí rastlinné dekorácie kedykoľvek v roku.
- Kučeravá biela alebo žltá orchidea je vanilka, obvyklé korenie. Jej kňučanie môže mať šalátový odtieň v závislosti od rozmanitosti rastliny. Na rozdiel od väčšiny príbuzných, jeho voňavé kvety sú odhalené len 1 deň, ale existuje veľa z nich na Liane a kvitnúce trvá niekoľko týždňov. Kučesné orchidey sú ľahko prispôsobené podmienkam obvyklého miestnosti.
- Likasta veľké formy veľké (až 15 cm) kvety umiestnené v každej šípke. Žltá orchidea je nenáročná na starostlivosť, aj keď veľkolepé a celkom zriedkavé.
Odrody rarity nie vždy indikuje jeho spôsobilosť. Niektoré rastliny dokonale prenášajú bežné podmienky miestnosti, potrebujú len v pravidelnom zalievaní a striekaní. Môžu plne odkazovať na všetkých. Hybridy vytvorené na nich sa vyznačujú veľkou škálou farieb. Po štúdiu typov orchideí s fotografiami a menami je možné nájsť tak, že uspokojí nenáročné, veľkosti, farbu.
Vďaka druhu orchidea na chuť, model kvetov nebude môcť mať jedinú inštanciu. Ale kolekcia je lepšia formovať tak, že časť rastlín kvitnú. Urobí to atraktívne v každom ročníku.